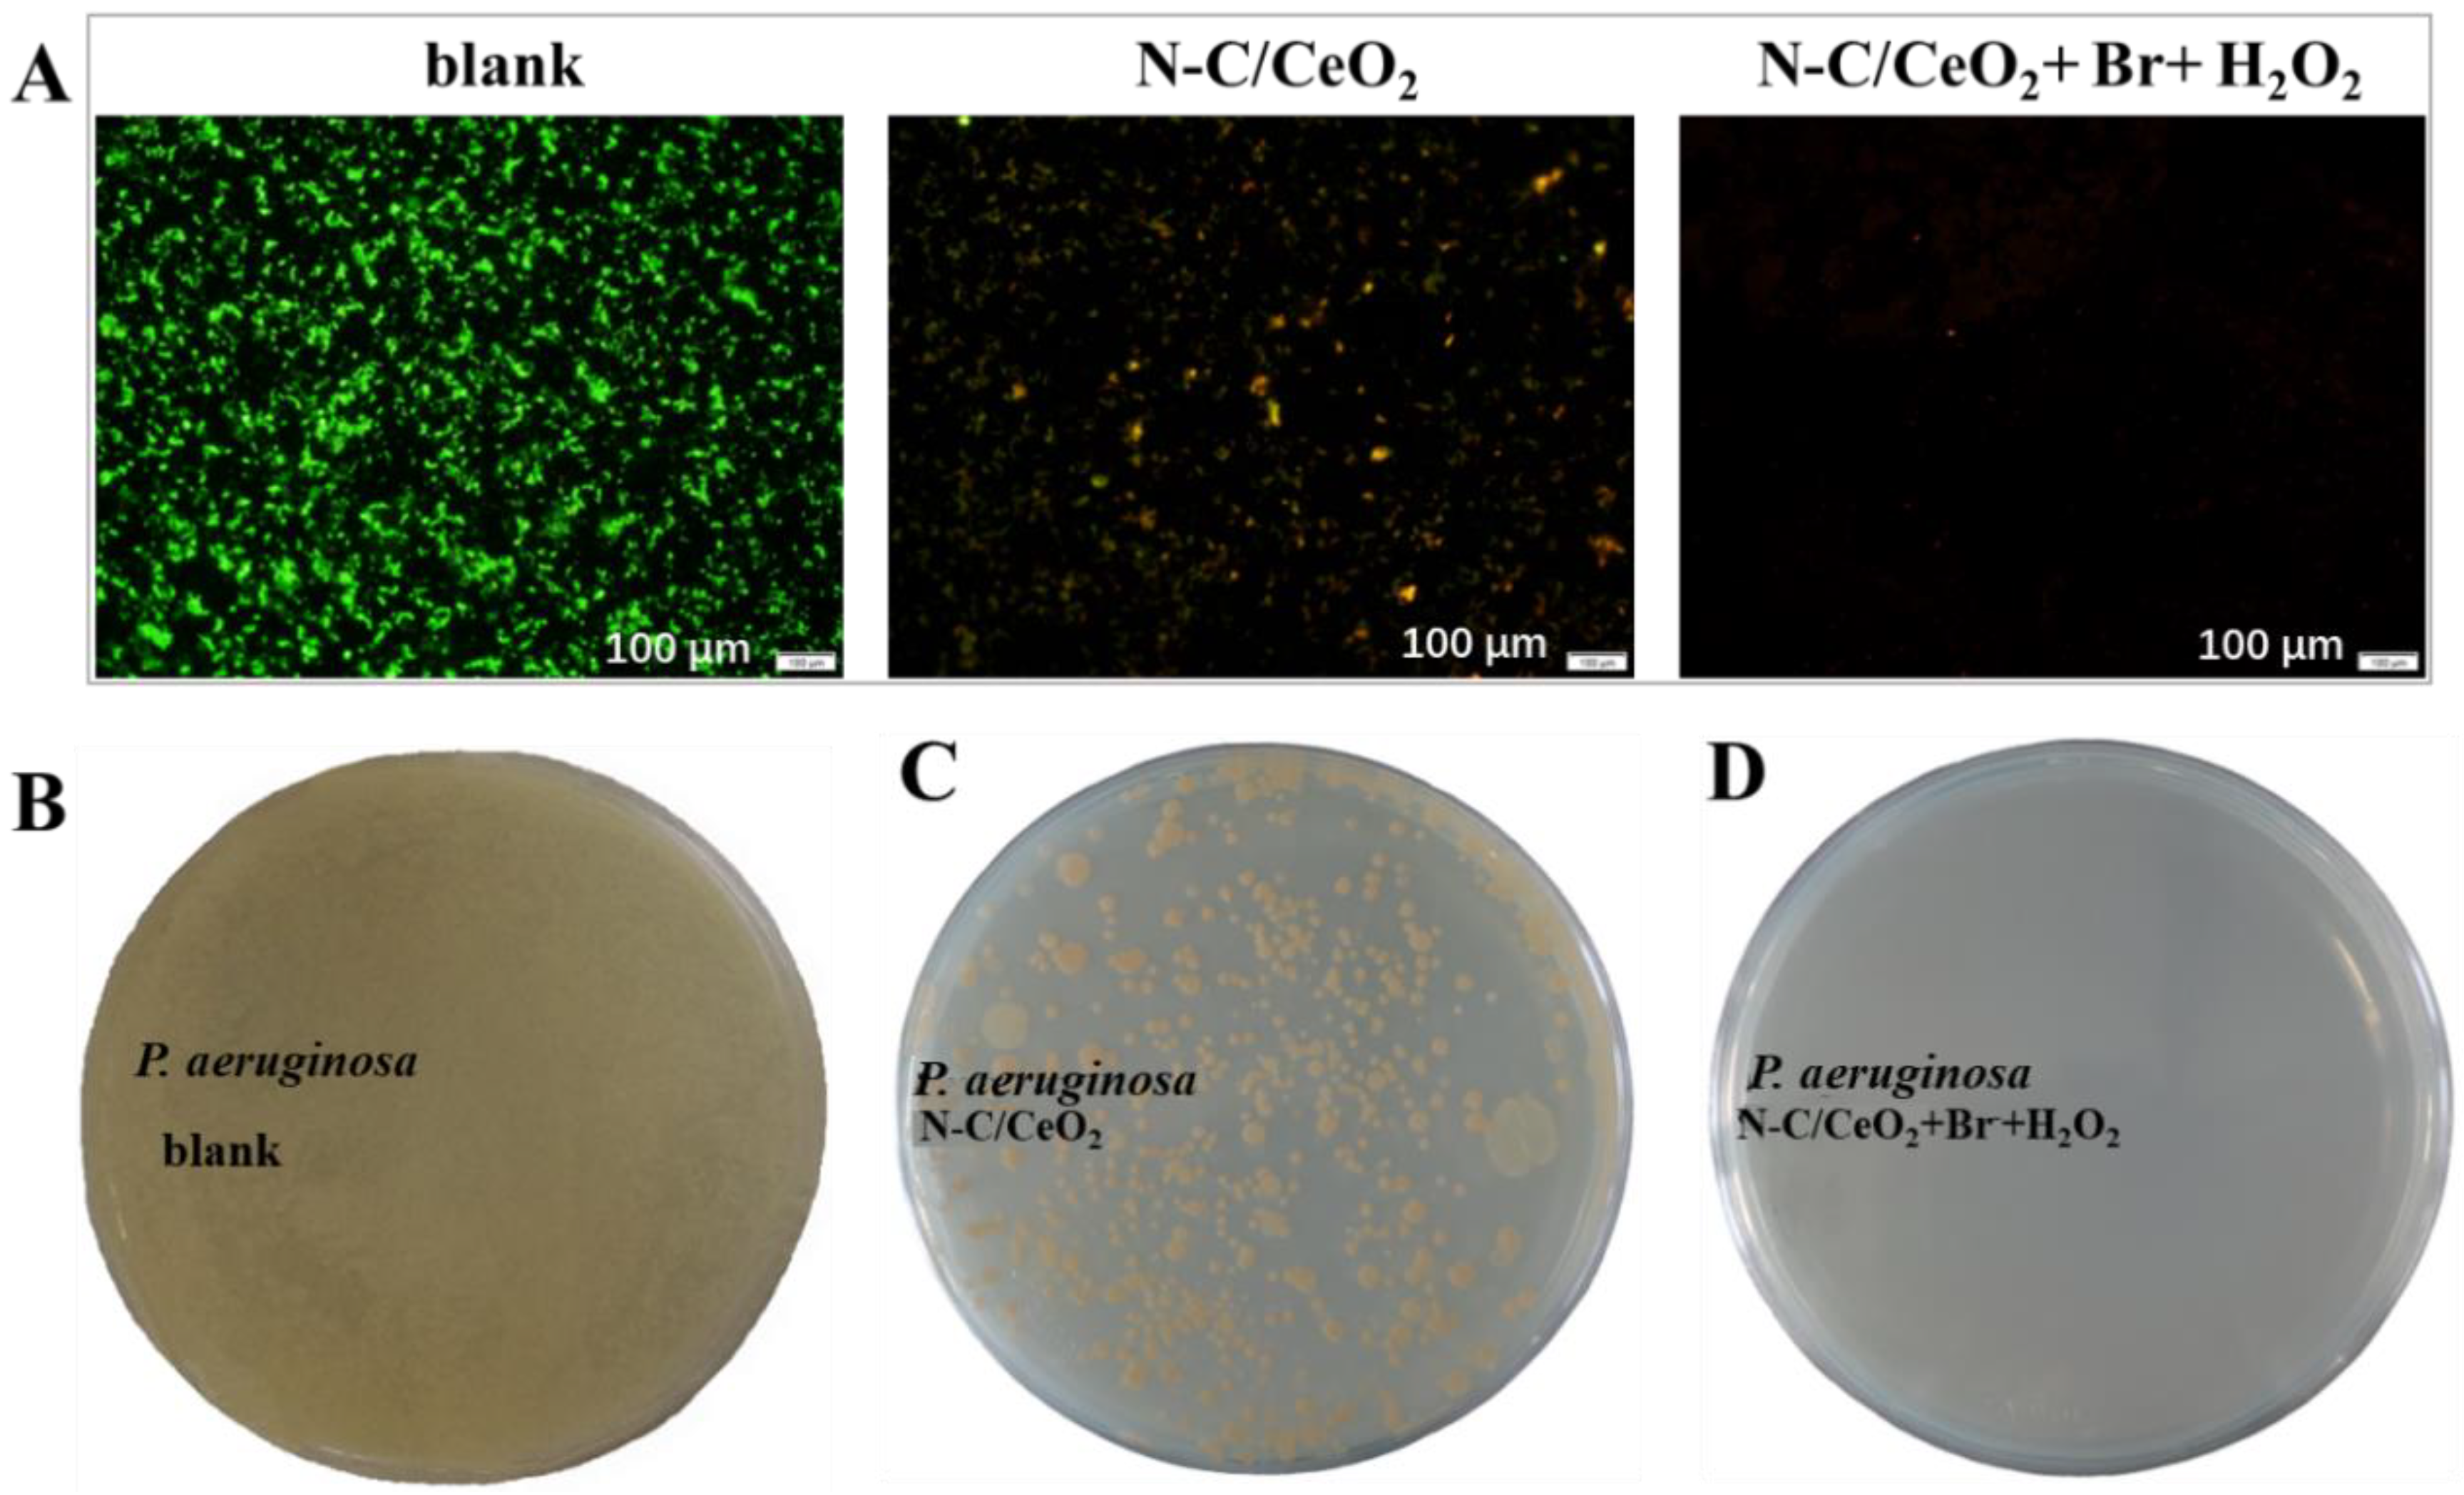

N-Doped Carbon/CeO2 Composite as a Biomimetic Catalyst for Antibacterial Application
Abstract
1. Introduction
2. Results and Discussion
2.1. Characterization
2.2. Haloperoxidase Mimicry Activity
2.3. Kinetics Constant Determination
2.4. Antibacterial Test
3. Methods
3.1. Reagents and Apparatus
3.2. Synthesis of N-C/CeO2 Composites
3.3. Haloperoxidase-like Activity of N-C/CeO2 Composites
3.4. Determination of Kinetic Constant
3.5. Bacterial Adhesion Tests
4. Conclusions
Supplementary Materials
Author Contributions
Funding
Institutional Review Board Statement
Informed Consent Statement
Data Availability Statement
Conflicts of Interest
References
- Mazurkiewicz, K.; Jeż-Walkowiak, J.; Michałkiewicz, M. Physicochemical and microbiological quality of rainwater harvested in underground retention tanks. Sci. Total Environ. 2022, 814, 152701. [Google Scholar] [CrossRef]
- Wang, J.; Wang, Y.; Zhang, D.; Xu, C.; Xing, R. Dual response mimetic enzyme of novel Co4S3/Co3O4 composite nanotube for antibacterial application. J. Hazard. Mater. 2020, 392, 122278. [Google Scholar] [CrossRef]
- Han, J.; Zhang, X.; Li, W.; Jiang, J. Low chlorine impurity might be beneficial in chlorine dioxide disinfection. Water Res. 2021, 188, 116520. [Google Scholar] [CrossRef]
- Luther, A.; Urfer, M.; Zahn, M.; Müller, M.; Wang, S.-Y.; Mondal, M.; Vitale, A.; Hartmann, J.-B.; Sharpe, T.; Monte, F.L.; et al. Chimeric peptidomimetic antibiotics against Gram-negative bacteria. Nature 2019, 576, 452–458. [Google Scholar] [CrossRef]
- Patteson, J.B.; Putz, A.T.; Tao, L.; Simke, W.C.; Bryant, L.H.; Britt, R.D.; Li, B. Biosynthesis of fluopsin C, a copper-containing antibiotic from Pseudomonas aeruginosa. Science 2021, 374, 1005–1009. [Google Scholar] [CrossRef]
- Jin, Y.; Yang, Y.; Duan, W.; Qu, X.; Wu, J. Synergistic and on-demand Release of Ag-AMPs loaded on porous silicon nanocarriers for antibacteria and wound healing. ACS Appl. Mater. Interfaces 2021, 13, 16127–16141. [Google Scholar] [CrossRef]
- Abdulsada, Z.; Kibbee, R.; Schwertfeger, D.; Princz, J.; DeRosa, M.; Örmeci, B. Fate and removal of silver nanoparticles during sludge conditioning and their impact on soil health after simulated land application. Water Res. 2021, 206, 117757. [Google Scholar] [CrossRef]
- Lv, L.; Yu, X.; Xu, Q.; Ye, C. Induction of bacterial antibiotic resistance by mutagenic halogenated nitrogenous disinfection byproducts. Environ. Pollut. 2015, 205, 291–298. [Google Scholar] [CrossRef]
- Stracy, M.; Snitser, O.; Yelin, I.; Amer, Y.; Parizade, M.; Katz, R.; Rimler, G.; Wolf, T.; Herzel, E.; Koren, G.; et al. Minimizing treatment-induced emergence of antibiotic resistance in bacterial infections. Science 2022, 375, 889–894. [Google Scholar] [CrossRef]
- Herget, K.; Frerichs, H.; Pfitzner, F.; Tahir, M.N.; Tremel, W. Functional enzyme mimics for oxidative halogenation reactions that combat biofilm formation. Adv. Mater. 2018, 30, e1707073. [Google Scholar] [CrossRef]
- de Boer, E.; Plat, H.; Tromp, M.G.M.; Wever, R.; Franssen, M.C.R.; van der Plas, H.C.; Meijer, E.M.; Schoemaker, H.E. Vanadium containing bromoperoxidase: An example of an oxidoreductase with high operational stability in aqueous and organic media. Biotechnol. Bioeng. 1987, 30, 607–610. [Google Scholar] [CrossRef] [PubMed]
- Sandy, M.; Carter-Franklin, J.N.; Martin, J.D.; Butler, A. Vanadium bromoperoxidase from Delisea pulchra: Enzyme-catalyzed formation of bromofuranone and attendant disruption of quorum sensing. Chem. Commun. 2011, 47, 12086–12088. [Google Scholar] [CrossRef] [PubMed]
- Butler, A.; Sandy, M. Mechanistic considerations of halogenating enzymes. Nature 2009, 460, 848–854. [Google Scholar] [CrossRef]
- Kristensen, J.B.; Meyer, R.L.; Laursen, B.S.; Shipovskov, S.; Besenbacher, F.; Poulsen, C.H. Antifouling enzymes and the biochemistry of marine settlement. Biotechnol. Adv. 2008, 26, 471–481. [Google Scholar] [CrossRef]
- Hasan, Z.; Renirie, R.; Kerkman, R.; Ruijssenaars, H.J.; Hartog, A.F.; Wever, R. Laboratory-evolved vanadium chloroperoxidase exhibits 100-fold higher halogenating activity at alkaline pH: Catalytic effects from first and second coordination sphere mutations. J. Biol. Chem. 2006, 281, 9738–9744. [Google Scholar] [CrossRef]
- Natalio, F.; Andre, R.; Hartog, A.F.; Stoll, B.; Jochum, K.P.; Wever, R.; Tremel, W. Vanadium pentoxide nanoparticles mimic vanadium haloperoxidases and thwart biofilm formation. Nat. Nanotechnol. 2012, 7, 530–535. [Google Scholar] [CrossRef]
- Assem, F.L.; Levy, L.S. A review of current toxicological concerns on vanadium pentoxide and other vanadium compounds: Gaps in knowledge and directions for future research. J. Toxicol. Env. Health B Crit. Rev. 2009, 12, 289–306. [Google Scholar] [CrossRef] [PubMed]
- Mimoun, H.; Saussine, L.; Daire, E.; Postel, M.; Fischer, J.; Weiss, R. Vanadium(V) peroxy complexes. New versatile biomimetic reagents for epoxidation of olefins and hydroxylation of alkanes and aromatic hydrocarbons. J. Am. Chem. Soc. 1983, 105, 3101–3110. [Google Scholar] [CrossRef]
- Yalcin, O.; Molinari Erwin, J.E.; Gerceker, D.; Onal, I.; Wachs, I.E. Role of local structure on catalytic reactivity: Comparison of methanol oxidation by aqueous bioinorganic enzyme mimic (vanadium haloperoxidase) and vanadia-based heterogeneous catalyst (Supported VO4/SiO2). ACS Catal. 2019, 10, 1566–1574. [Google Scholar] [CrossRef]
- Colpas, G.J.; Hamstra, B.J.; Kampf, J.W.; Pecoraro, V.L. Functional models for vanadium haloperoxidase: Reactivity and mechanism of halide oxidation. J. Am. Chem. Soc. 1996, 118, 3469–3478. [Google Scholar] [CrossRef]
- Conte, V.; Coletti, A.; Floris, B.; Licini, G.; Zonta, C. Mechanistic aspects of vanadium catalysed oxidations with peroxides. Coord. Chem. Rev. 2011, 255, 2165–2177. [Google Scholar] [CrossRef]
- Cheng, Y.; Liang, L.; Ye, F.; Zhao, S. Ce-MOF with intrinsic haloperoxidase-like activity for ratiometric colorimetric detection of hydrogen peroxide. Biosensors 2021, 11, 204. [Google Scholar] [CrossRef] [PubMed]
- Hu, M.; Korschelt, K.; Viel, M.; Wiesmann, N.; Kappl, M.; Brieger, J.; Landfester, K.; Therien-Aubin, H.; Tremel, W. Nanozymes in nanofibrous mats with haloperoxidase-like activity to combat biofouling. ACS Appl. Mater. Interfaces 2018, 10, 44722–44730. [Google Scholar] [CrossRef] [PubMed]
- He, X.; Tian, F.; Chang, J.; Bai, X.; Yuan, C.; Wang, C.; Neville, A. Haloperoxidase mimicry by CeO2–x nanorods of different aspect ratios for antibacterial performance. ACS Sustain. Chem. Eng. 2020, 8, 6744–6752. [Google Scholar] [CrossRef]
- Herget, K.; Hubach, P.; Pusch, S.; Deglmann, P.; Gotz, H.; Gorelik, T.E.; Gural’skiy, I.A.; Pfitzner, F.; Link, T.; Schenk, S.; et al. Haloperoxidase Mimicry by CeO2-x Nanorods Combats Biofouling. Adv. Mater. 2017, 29, e1603823. [Google Scholar] [CrossRef]
- Wang, N.; Li, W.; Ren, Y.; Duan, J.; Zhai, X.; Guan, F.; Wang, L.; Hou, B. Investigating the properties of nano core-shell CeO2@C as haloperoxidase mimicry catalyst for antifouling applications. Colloids Surf. A: Physicochem. Eng. Asp. 2021, 608, 125592. [Google Scholar] [CrossRef]
- Barth, C.; Laffon, C.; Olbrich, R.; Ranguis, A.; Parent, P.; Reichling, M. A perfectly stoichiometric and flat CeO2(111) surface on a bulk-like ceria film. Sci. Rep. 2016, 6, 21165. [Google Scholar] [CrossRef]
- Baldim, V.; Yadav, N.; Bia, N.; Graillot, A.; Loubat, C.; Singh, S.; Karakoti, A.S.; Berret, J.-F. Polymer-coated cerium oxide nanoparticles as oxidoreductase-like catalysts. ACS Appl. Mater. Interfaces 2020, 12, 42056–42066. [Google Scholar] [CrossRef] [PubMed]
- Baldim, V.; Bedioui, F.; Mignet, N.; Margaill, I.; Berret, J.F. The enzyme-like catalytic activity of cerium oxide nanoparticles and its dependency on Ce3+ surface area concentration. Nanoscale 2018, 10, 6971–6980. [Google Scholar] [CrossRef]
- Dong, Y.; Deng, Y.; Zeng, J.; Song, H.; Liao, S. A high-performance composite ORR catalyst based on the synergy between binary transition metal nitride and nitrogen-doped reduced graphene oxide. J. Mater. Chem. A 2017, 5, 5829–5837. [Google Scholar] [CrossRef]
- Wang, H.; Maiyalagan, T.; Wang, X. Review on recent progress in nitrogen-doped graphene: Synthesis, characterization, and its potential applications. ACS Catal. 2012, 2, 781–794. [Google Scholar] [CrossRef]
- Du, X.; Zhang, D.; Shi, L.; Gao, R.; Zhang, J. Morphology Dependence of Catalytic Properties of Ni/CeO2 Nanostructures for Carbon Dioxide Reforming of Methane. J. Phys. Chem. C 2012, 116, 10009–10016. [Google Scholar] [CrossRef]
- Maiti, S.; Dhawa, T.; Mallik, A.K.; Mahanty, S. CeO2@C derived from benzene carboxylate bridged metal-organic frameworks: Ligand induced morphology evolution and influence on the electrochemical properties as a lithium-ion battery anode. Sustain. Energy Fules 2017, 1, 288–298. [Google Scholar] [CrossRef]
- de Boer, E.; Wever, R. The reaction mechanism of the novel vanadium-bromoperoxidase. A steady-state kinetic analysis. J. Biol. Chem. 1988, 263, 12326–12332. [Google Scholar] [CrossRef]
- Zhai, X.; Ju, P.; Guan, F.; Duan, J.; Wang, N.; Zhang, Y.; Li, K.; Hou, B. Biofilm inhibition mechanism of BiVO4 inserted zinc matrix in marine isolated bacteria. J. Mater. Sci. Technol. 2021, 75, 86–95. [Google Scholar] [CrossRef]
- Liu, M.; Zhao, H.; Chen, S.; Yu, H.; Quan, X. Interface engineering catalytic graphene for smart colorimetric biosensing. ACS Nano 2012, 6, 3142–3151. [Google Scholar] [CrossRef]
- Wang, N.; Li, B.; Qiao, F.; Sun, J.; Fan, H.; Ai, S. Humic acid-assisted synthesis of stable copper nanoparticles as a peroxidase mimetic and their application in glucose detection. J. Mater. Chem. B 2015, 3, 7718–7723. [Google Scholar] [CrossRef]
- Kim, D.J.; Chung, S.G.; Lee, S.H.; Choi, J.W. Relation of microbial biomass to counting units for Pseudomonas aeruginosa. Afr. J. Microbiol. Res. 2012, 6, 4620–4622. [Google Scholar]

| Substrates | Km (μ·mol·L−1) | vmax (μmol·L−1·min−1) |
|---|---|---|
| H2O2 (mmol·L−1) | 0.246 | 0.669 |
| NH4Br (mmol·L−1) | 173 | 1.11 |
| PR (mmol·L−1) | 0.0130 | 2.48 |
| Materials | Substrates | Km (μmol·L−1) |
|---|---|---|
| N-C/CeO2 composites | H2O2 | 0.246 |
| Br− | 173 | |
| vanadium bromoperoxidase (V-BPO) | H2O2 | 22.0 |
| Br− | 18.1 |
Disclaimer/Publisher’s Note: The statements, opinions and data contained in all publications are solely those of the individual author(s) and contributor(s) and not of MDPI and/or the editor(s). MDPI and/or the editor(s) disclaim responsibility for any injury to people or property resulting from any ideas, methods, instructions or products referred to in the content. |
© 2023 by the authors. Licensee MDPI, Basel, Switzerland. This article is an open access article distributed under the terms and conditions of the Creative Commons Attribution (CC BY) license (https://creativecommons.org/licenses/by/4.0/).
Share and Cite
Wang, N.; Zhai, X.; Guan, F.; Zhang, R.; Hou, B.; Duan, J. N-Doped Carbon/CeO2 Composite as a Biomimetic Catalyst for Antibacterial Application. Int. J. Mol. Sci. 2023, 24, 2445. https://doi.org/10.3390/ijms24032445
Wang N, Zhai X, Guan F, Zhang R, Hou B, Duan J. N-Doped Carbon/CeO2 Composite as a Biomimetic Catalyst for Antibacterial Application. International Journal of Molecular Sciences. 2023; 24(3):2445. https://doi.org/10.3390/ijms24032445
Chicago/Turabian StyleWang, Nan, Xiaofan Zhai, Fang Guan, Ruiyong Zhang, Baorong Hou, and Jizhou Duan. 2023. "N-Doped Carbon/CeO2 Composite as a Biomimetic Catalyst for Antibacterial Application" International Journal of Molecular Sciences 24, no. 3: 2445. https://doi.org/10.3390/ijms24032445
APA StyleWang, N., Zhai, X., Guan, F., Zhang, R., Hou, B., & Duan, J. (2023). N-Doped Carbon/CeO2 Composite as a Biomimetic Catalyst for Antibacterial Application. International Journal of Molecular Sciences, 24(3), 2445. https://doi.org/10.3390/ijms24032445

